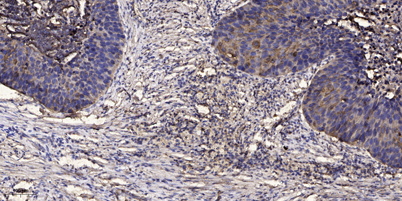

LRRK2 rabbit pAb
 One-click to copy product information
One-click to copy product information$148.00/50µL $248.00/100µL
| 50 µL | $148.00 |
| 100 µL | $248.00 |
Overview
| Product name: | LRRK2 rabbit pAb |
| Reactivity: | Human;Mouse |
| Source: | Rabbit |
| Dilutions: | IHC-p 1:50-300 |
| Immunogen: | Synthesized peptide derived from part region of human protein |
| Storage: | -20°C/1 year |
| Clonality: | Polyclonal |
| Isotype: | IgG |
| Concentration: | 1 mg/ml |
| Observed Band: | 277kD |
| GeneID: | 120892 |
| Human Swiss-Prot No: | Q5S007 |
| Cellular localization: | Cytoplasmic vesicle . Perikaryon . Golgi apparatus membrane ; Peripheral membrane protein . Cell projection, axon . Cell projection, dendrite . Endoplasmic reticulum membrane ; Peripheral membrane protein . Cytoplasmic vesicle, secretory vesicle, synaptic vesicle membrane . Endosome . Lysosome . Mitochondrion outer membrane ; Peripheral membrane protein . Colocalized with RAB29 along tubular structures emerging from Golgi apparatus (PubMed:23395371). Localizes to endoplasmic reticulum exit sites (ERES), also known as transitional endoplasmic reticulum (tER) (PubMed:25201882). . |
| Background: | This gene is a member of the leucine-rich repeat kinase family and encodes a protein with an ankryin repeat region, a leucine-rich repeat (LRR) domain, a kinase domain, a DFG-like motif, a RAS domain, a GTPase domain, a MLK-like domain, and a WD40 domain. The protein is present largely in the cytoplasm but also associates with the mitochondrial outer membrane. Mutations in this gene have been associated with Parkinson disease-8. [provided by RefSeq, Jul 2008], |

 Manual
Manual